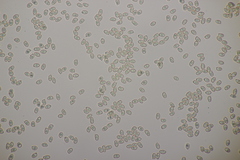
Ramaria gracilis

Ramaria gracilis: taxon details and analytics
- Domain
- Kingdom
- Fungi
- Phylum
- Basidiomycota
- Class
- Agaricomycetes
- Order
- Gomphales
- Family
- Gomphaceae
- Genus
- Ramaria
- Species
- Ramaria gracilis
- Scientific Name
- Ramaria gracilis
Summary description from Wikipedia:
Ramaria gracilis
Ramaria gracilis in languages:
- Bokmål
- duftkorallsopp
- Catalan
- peu de rata anisat
- Czech
- kuřátka něžná
- Danish
- Anis-koralsvamp
- Dutch
- Anijskoraalzwam
- Finnish
- anishaarakas
- French
- Ramaire gracile
- Hungarian
- karcsú korallgomba
- Russian
- Рамария стройная
- Swedish
- Anisfingersvamp
Images from inaturalist.org observations:
We recommend you sign up for this excellent, free service.
Parent Taxon
Sibling Taxa
- Formosae
- Ramaria acris
- Ramaria acrisiccescens
- Ramaria acutissima
- Ramaria ambigua
- Ramaria ammophila
- Ramaria amyloidea
- Ramaria anziana
- Ramaria apiculata
- Ramaria araiospora
- Ramaria argentea
- Ramaria armeniaca
- Ramaria aurantiisiccescens
- Ramaria aurea
- Ramaria aureorhiza
- Ramaria australiana
- Ramaria avellaneovertex
- Ramaria basirobusta
- Ramaria bataillei
- Ramaria bonii
- Ramaria boreimaxima
- Ramaria botrytis
- Ramaria botrytoides
- Ramaria bourdotiana
- Ramaria broomei
- Ramaria brunneicontusa
- Ramaria calvodistalis
- Ramaria capitata
- Ramaria cartilaginea
- Ramaria caulifloriformis
- Ramaria cedretorum
- Ramaria celerivirescens
- Ramaria chocoensis
- Ramaria cladoniae
- Ramaria concolor
- Ramaria conjunctipes
- Ramaria corrugata
- Ramaria coulterae
- Ramaria cyaneigranosa
- Ramaria cystidiophora
- Ramaria decurrens
- Ramaria divaricata
- Ramaria eosanguinea
- Ramaria fagetorum
- Ramaria fennica
- Ramaria filicicola
- Ramaria flava
- Ramaria flavescens
- Ramaria flavigelatinosa
- Ramaria flavobrunnescens
- Ramaria flavoides
- Ramaria flavosalmonicolor
- Ramaria flavosaponaria
- Ramaria flavula
- Ramaria foetida
- Ramaria formosa
- Ramaria fragillima
- Ramaria fumigata
- Ramaria gelatiniaurantia
- Ramaria gelatinosa
- Ramaria gracilis
- Ramaria grandis
- Ramaria gypsea
- Ramaria hemirubella
- Ramaria hilaris
- Ramaria holorubella
- Ramaria ignicolor
- Ramaria incongrua
- Ramaria junquilleo-vertex
- Ramaria junquilleovertex
- Ramaria karstenii
- Ramaria krieglsteineri
- Ramaria largentii
- Ramaria leptoformosa
- Ramaria longispora
- Ramaria lorithamnus
- Ramaria lutea
- Ramaria maculatipes
- Ramaria magnifica
- Ramaria magnipes
- Ramaria mairei
- Ramaria marrii
- Ramaria molleriana
- Ramaria murrillii
- Ramaria neoformosa
- Ramaria obtusissima
- Ramaria pallida
- Ramaria patagonica
- Ramaria perfluopunicea
- Ramaria persicina
- Ramaria piedmontiana
- Ramaria praecox
- Ramaria pseudogracilis
- Ramaria purpureopallida
- Ramaria purpurissima
- Ramaria pusilla
- Ramaria pyrispora
- Ramaria radicans
- Ramaria rainierensis
- Ramaria rasilispora
- Ramaria rasilisporoides
- Ramaria rotundispora
- Ramaria rubella
- Ramaria rubiginosa
- Ramaria rubribrunnescens
- Ramaria rubricarnata
- Ramaria rubrievanescens
- Ramaria rubripermanens
- Ramaria rufescens
- Ramaria safraniolens
- Ramaria samuelsii
- Ramaria sandaracina
- Ramaria sanguinea
- Ramaria schildii
- Ramaria sclerocarnosa
- Ramaria soluta
- Ramaria spinulosa
- Ramaria strasseri
- Ramaria stricta
- Ramaria stuntzii
- Ramaria suaveolens
- Ramaria subaurantiaca
- Ramaria subbotrytis
- Ramaria subtilis
- Ramaria subviolacea
- Ramaria suecica
- Ramaria synaptopoda
- Ramaria testaceoflava
- Ramaria testaceoviolacea
- Ramaria testaceoviridis
- Ramaria thiersii
- Ramaria thindii
- Ramaria toxica
- Ramaria tsugina
- Ramaria valdiviana
- Ramaria velocimutans
- Ramaria verlotensis
- Ramaria versatilis
- Ramaria vinosimaculans
- Ramaria violaceibrunnea
- Ramaria watlingii
- Ramaria xanthosperma